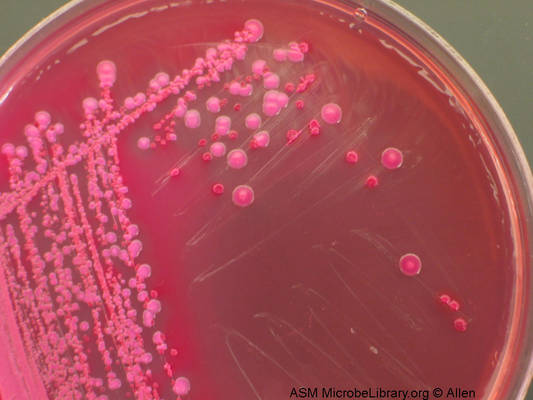

Po najnovejših znanstvenih spoznanjih je mogoče natančno, predvsem pa hitro in poceni diagnosticirati nekatere od najnevarnejših in proti zdravljenju z antibiotiki najbolj odpornih vrst bakterijskih okužb. Dobra novica je tudi, da je ta postopek mogoče opraviti z opremo, ki jo ima že zdaj večina bolnišnic v Evropi.
Nekatere bakterije so postopoma napredovale in razvile odpornost proti antibiotikom, s katerimi se jih je dalo še pred časom uspešno odpraviti. V minulih nekaj letih so znanstveniki našli dokaze, da so postale določene bakterije odporne tudi proti kolistinu, antibiotiku, ki ga sicer uporabljajo kot zadnjo obrambno črto. Na letošnjem evropskem kongresu kliničnih mikrobiologov in infektologov na Dunaju je skupina francoskih in britanskih znanstvenikov poročala, da so se usposobili za testiranje, ki zelo hitro pokaže, ali so določene bakterije odporne proti kolistinu ali ne – pa tudi to, kako hitro se lahko ta odpornost prenese na druge bakterije.
Odkritje je izredno pomembno, saj morebitno spoznanje o odpornosti bakterij med drugim pomeni, da je treba ogrožene bolnike umakniti v karanteno in s tem preprečiti širjenje okužbe ter krepitev bakterijske odpornosti.
Prof. dr. Laurent Dortet z Univerze v južnem Parizu je do teh spoznanj prišel med raziskovanjem na londonskem Imperialnem kolidžu, kjer je sodeloval z dr. Geraldom Larrouy-Maumusom in prof. dr. Allainom Fillouxom. Trojica znanstvenikov je proučevala bakteriji Escherichia coli in Klebsiella pneumoniae. Obe sodita v skupino enterobakterij, ki povzročajo gastroenteritis, vnetje sečil in pljučne bolezni, kot sta bronhitis in pljučnica. Obe bakteriji lahko izzoveta tudi sepso.
Nekateri sevi teh bakterij so odporni proti skoraj vsem antibiotikom. Takšni sevi lahko ustvarijo encime, ki ovirajo delovanje antibiotikov, pri čemer gre za širok spekter encimov betalaktamaze (ovirajo delovanje penicilina in cefalosporinov) in karbapenemaze (ovirajo delovanje imipenema in meropenema). To pomeni, da je pri odpravljanju bakterij, ki so odporne proti vsem drugim antibiotikom, učinkovit le še kolistin. Žal pa so nekatere od teh v zadnjem času razvile odpornost celo proti kolistinu, je opozoril Dortet.
Dve vrsti odpornosti
»Plazmidna kodirana odpornost vzbuja posebno skrb, ker se širi zelo hitro, tako da lahko celo kolistin postane povsem neučinkovit. Če hitro odkrijemo bakterijo s to vrsto odpornosti, lahko uvedemo ukrepe, s katerimi preprečimo njeno širjenje – in to z osamitvijo bolnika v posebni sobi, kjer ga neguje ustrezno osebje,« je poudaril Dortet.
Dortetova skupina je testirala 134 kolonij bakterij z masnim spektrometrom. To napravo ima večina bolnišničnih laboratorijev in jo uporabljajo za analiziranje različnih molekul. Znanstveniki so ugotovili, da z masnim spektrometrom lahko ugotovijo ne le, katere bakterije so odporne proti kolistinu, temveč tudi, katere imajo plazmidno kodirano odpornost. Po Dortetovih besedah traja test le 15 minut in stane za en analiziran vzorec manj kot dolar.
»Spodbudno je, da se ta tehnika opira na naprave, ki jih že imajo v večini bolnišnic. To pomeni, da je mogoče delati hitro in poceni ter se tako hitro in učinkovito vključiti v boj proti odpornosti bakterij proti zdravilom,« je dodal Larrouy-Maumus.
Raziskovalci so se letos poleti s centrom za inovacije in prenos tehnologij v okviru Imperialnega kolidža pospešeno ukvarjali s patentiranjem tehnike testiranja bakterij, ki bo primerna za široko uporabo v bolnišničnih laboratorijih. Na dunajskem kongresu smo izvedeli, da so lahko takšna testiranja zelo koristna tudi v veterini, kajti v veterinarski medicini so že opazili visoko raven odpornosti proti kolistinu. Poleg tega je mogoče to testiranje uporabiti pri novih zdravilih, in sicer pri ugotavljanju, ali ta lahko odpravijo bakterijsko odpornost oziroma znova spodbudijo občutljivost bakterij za kolistin.
Nevarna prisotnost
Po splošnih ocenah sepsa po vsem svetu vsako leto prizadene okoli 30 milijonov ljudi. Če se ne ukrepa odločno in hitro, lahko pride do odpovedi več organov in smrti. Boj proti sepsi je seveda močno otežen, če so jo povzročile bakterije, odporne proti antibiotikom.
Dr. Joakim Isendahl z Inštituta Karolinska v Stockholmu je na dunajskem kongresu predstavil del svoje doktorske disertacije. Med drugim je ugotovil, da lahko v nekaterih primerih bakterije, odporne proti zdravilom, iz sečnega trakta ali črevesja preidejo v krvni obtok. V nekaterih drugih primerih, pravi Isendahl, pa lahko bakterije, ki jih odkrijejo v bolnikovem urinu oziroma blatu, svojo odpornost proti zdravilom prenesejo na druge bakterije v organizmu – nato pa te povzročijo sepso.
Na Švedskem razkrili
Znanstveniki so se med raziskavo osredotočili na določene bakterije, in sicer na E. coli, ki ustvarja encime, imenovane betalaktamaze širokega spektra. Ti encimi omogočajo bakterijam, da uničijo različne vrste antibiotikov, vključno s penicilinom in tretjo generacijo cefalosporina. Zato jih imenujejo enterobakterije, ki ustvarjajo betalaktamaze širokega spektra, skrajšano EPE.
Echerichia coli in Klebisella pneumoniae Foto: wikipedia
Raziskovalci na Švedskem so med letoma 2007 in 2012 proučevali vse ljudi, pri katerih so v vzorcih urina ali blata našli omenjene bakterije. Bilo jih je več kot 22.000. Dobljene podatke so primerjali z dvakrat večjim številom ljudi, pri katerih laboratorijske preiskave niso ugotovile EPE. Obe skupini so medicinsko spremljali šest let, da bi ugotovili, ali je pri kom od njih prišlo do sepse.
Ta velika množica podatkov je pokazala, da je pri ljudeh, ki imajo v črevesju EPE, 57-krat večje tveganje za razvoj okužbe krvnega obtoka z EPE, od povprečja, ki velja za celotno prebivalstvo. Pri tistih, pri katerih so EPE našli v urinu, pa je to tveganje še večje, in to kar 113-krat večje od povprečja za celotno prebivalstvo. Med šestletno študijo je za okužbo krvnega obtoka z EPE zbolelo dva odstotka ljudi, pri katerih so odkrili EPE v črevesju, in štirje odstotki ljudi z EPE v sečilih. V splošnem prebivalstvu je bil delež obolelih za sepso 0,02 odstotka.
Zdravila zadnje
»Čeprav so okužbe krvnega obtoka redke, so njihove posledice izredno hude. Zdravljenje z zdravili se mora zato začeti takoj, ko je mogoče. Podatek, ali ima bolnik pred tem izvid EPE in kako dolgo je minilo od odkritja EPE, zdravnikom pomaga pri odločitvi, ali bolnik nujno potrebuje zdravila zadnje obrambne črte ali ne. To je izredno pomembno, saj moramo imeti do vseh zdravil kar se da razumen pristop, če hočemo, da bodo ta še naprej učinkovita. Ugotovili smo, da je največje tveganje za sepso v prvih dneh in tednih po odkritju bakterij v urinu in blatu, povečano tveganje pa nato obstaja še tri leta.«
Študijo so izpeljali izključno s podatki iz Švedske, saj tamkajšnja zakonodaja določa, da je treba izvid EPE prijaviti državnemu uradu za javno zdravstvo. Raziskovalci so prepričani, da veljajo njihove ugotovitve tudi za druge države, v katerih se pojavlja podoben delež izvidov EPE – torej za preostale države na severu Evrope.
Še ne vedo natanko,
»Vemo, da so nekatere EPE, kot je ena od vrst Escherichie coli, imenovana ST 131, nagnjene k temu, da zasedejo črevesje in od tam povzročijo okužbo krvnega obtoka. Prav tako je možno, da kakšna razmeroma nenevarna bakterija svojo odpornost proti antibiotikom prenese na nevarnejše bakterije v našem organizmu, ki nato povzročijo sepso.«













